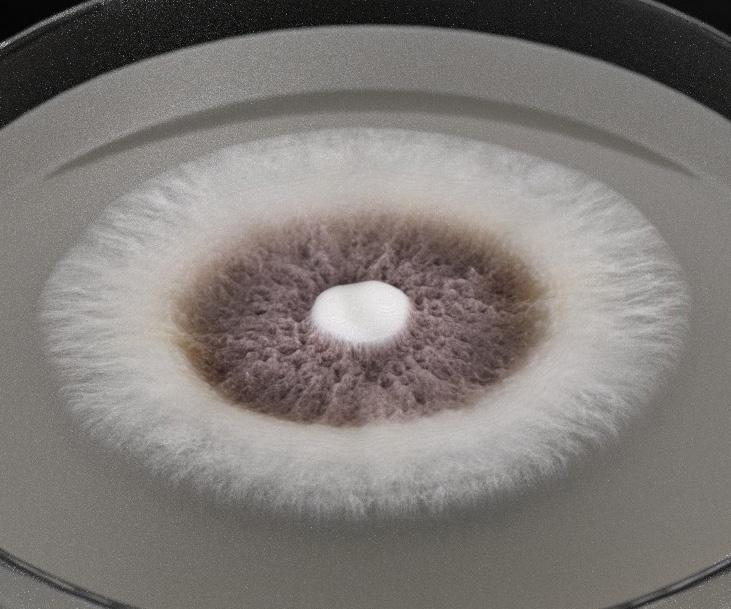

André Martins
Gerente Geral Koppert Andina

Desde o início deste ano, a Koppert Brasil passou por uma fase de expansão, assumindo a liderança da Koppert Andina, que abrange Chile, Colômbia, Peru e Equador. Nesta entrevista exclusiva, tivemos o privilégio de conversar com André Martins, Gerente Geral da Koppert Andina, para explorar os detalhes dessa significativa transição e compreender melhor os impactos e oportunidades que surgem com essa nova liderança.
BioJournal: Qual é a estratégia da Koppert para expandir o uso de biológicos entre os produtores e aumentar a produção e produtividade?
André Martins: O Peru se destaca pela fruticultura, sendo o maior produtor de blueberry e um dos principais exportadores de frutas, o que o torna nosso mercado-alvo. Além disso, há uma presença significativa de cana-de-açúcar, embora em menor escala que no Brasil. No Chile, encontramos também uma forte presença na fruticultura, horticultura e cultivo de tomate. Na Colômbia, estamos ativos na produção de rosas e flores ornamentais, com planos futuros de expansão para culturas como café, abacate e outras frutas. No Equador, predominam culturas como banana orgânica, cacau e cana-de-açúcar,
representando um mercado em ascensão. Ademais, o mercado de sementes, com produção no Chile e Peru, apresenta-se como uma grande oportunidade para a Koppert.
Falando de time, como está sendo o processo de expansão?
Atualmente, estamos utilizando o time existente enquanto realizamos uma reestruturação do trabalho. Nossa meta é iniciar o aumento do quadro de funcionários a partir de 2025, como parte de uma mudança na nossa abordagem operacional. Estamos focados não apenas em fortalecer nossa equipe de vendas e desenvolvimento de mercado, mas também em aprimorar nossa estratégia de distribuição, visando alcançar um número ainda maior de produtores.
4
Qual a expectativa da Koppert Global em relação à liderança do Brasil?
Com a proximidade logística que agora desfrutamos, planejamos introduzir alguns dos produtos brasileiros nos países andinos. Aproximando nossa logística, visamos garantir preços mais competitivos e entregas mais rápidas. Nossa intenção é aplicar com sucesso a expertise que adquirimos no Brasil também nos países andinos.
Qual a expectativa de expansão de mercado?
Nos próximos três anos, almejamos alcançar aproximadamente 10% do faturamento da Koppert Brasil nos países andinos. Com a introdução de novos produtos, queremos superar essa meta.
O que você sentiu até agora vivendo no Chile?
O Brasil é líder mundial no uso de biológicos, com uma taxa de adoção de cerca de 30%. Nos países andinos, essa taxa é significativamente menor, variando entre 7 a 8%. No entanto, observamos uma crescente aceitação dos produtos biológicos nessa região, indicando uma tendência positiva para sua adoção futura.
O que você tem visto de desafios?
Atualmente, enfrentamos o desafio de lidar com produtores que ainda mantêm ceticismo em relação aos biológicos.
Dos quatro países, algum tem se sobressaído?
A fruticultura no Chile é uma área de destaque. As grandes empresas do setor, que são importantes agroexportadoras, têm demonstrado uma excelente receptividade aos produtos biológicos. Observo uma maior penetração desses produtos no mercado chileno.
Os produtores têm a real noção sobre o crescimento rápido dos biológicos no Brasil ou eles se espantam?
A maioria das pessoas não tem ciência do rápido crescimento que o Brasil está
experimentando nesse campo. Elas reconhecem que o Brasil está bem estabelecido na área de biológicos, mas desconhecem os números por trás desse progresso. Quando apresento esses dados, elas ficam impressionadas com o potencial de crescimento. Na verdade, todos compartilham o desejo de ver esse avanço, pois o mercado já demonstra uma preferência por produtos sustentáveis. Anteriormente, a produção de vinho no Chile não era frequentemente associada à sustentabilidade, mas hoje em dia essa mentalidade está se tornando mais comum.
Imagino que outros cultivos também tenham essa tendência, certo?
Com certeza. As grandes agroexportadoras estão seguindo a tendência dos biológicos, buscando expandir e comercializar uma produção mais sustentável para seus clientes. O movimento em direção aos biológicos é irreversível.
E como tem sido seu dia a dia, seu trabalho?
Atualmente resido em Santiago, Chile. Nos primeiros meses, concentrei meus esforços no Chile, embora estivesse atento a todos os países da região. Agora, tenho direcionado minha atenção também para o Peru, gradualmente aprofundando minha estratégia em cada país.
Como tem sido a discussão do Sistema Integrado Koppert no Chile? Inicialmente, eles consideram que se trata de um manejo biológico completo, mas na verdade não é. Atualmente, adotamos o manejo integrado, que combina abordagens químicas e biológicas, e isso ajuda a esclarecer equívocos. Ao explicar para uma empresa que até então não estava familiarizada com os biológicos, o potencial de redução no uso de produtos químicos, juntamente com os benefícios para o cultivo, como a redução de doenças e pragas, a aceitação dos biológicos aumenta.
Empresas mais tradicionais têm direcionado esforços para a questão do bioinsumo nos países andinos?
Essas empresas têm direcionado esforços nesse sentido, embora não com a mesma intensidade observada no Brasil. Enquanto o Brasil está mais avançado nesse aspecto, os outros países estão progredindo mais lentamente, porém seguindo uma trajetória semelhante.
Como você tem sentido na parte de agricultura?
No ano passado, houve uma situação desfavorável para a produção de frutas no Chile devido ao excesso de chuvas nos países andinos. Isso resultou em queda na produtividade e nos preços. Atualmente, com a transição de El Niño para La Niña, espera-se um ano com menos chuvas, o que indica uma expectativa de excelente produção e preços estáveis. Essa perspectiva também se aplica ao Peru.
Qual a mensagem que fica frente a essa expansão, a oportunidade que o Brasil vem buscando em relação aos países andinos?
Acredito que a Koppert conseguirá compartilhar sua expertise e contribuir para a produção de uma agricultura mais sustentável em todos os países andinos. Com isso, teremos à disposição produtos de melhor qualidade, que causam menos impacto ao meio ambiente. É extremamente gratificante fazer parte desse processo e testemunhar sua concretização.
5 BioJournal | Ano 11 | Edição 01 | TRIMESTRAL 2024
CAPA
Koppert Brasil assume a operação da companhia nos países andinos e passa a gerir a Koppert América do Sul
Em uma jogada estratégica para fortalecer sua presença na América do Sul, a Koppert Brasil assumiu o controle das unidades da companhia nos países andinos, incluindo Chile, Colômbia, Equador e Peru. Esta expansão de negócios marca um novo capítulo na história da Koppert, consolidando sua posição como líder em soluções de controle biológico na região.
A subsidiária brasileira, já encarregada das operações na Argentina, Uruguai e Paraguai, agora assume o comando da Koppert América do Sul. Sob a direção do diretor comercial, Gustavo Herrmann, e do diretor industrial, Danilo Pedrazzoli, a Koppert Brasil está preparada para liderar e impulsionar o crescimento da empresa em toda a região.
Anteriormente, a gestão das unidades nos países andinos estava sob a supervisão das diretorias na Holanda e nos Estados Unidos. No entanto, a centralização da gestão na Koppert Brasil visa facilitar a implementação

do controle biológico e aumentar a presença da empresa na América do Sul. “A estratégia é centralizar a gestão para, com a proximidade física, acelerar a adoção do controle biológico e ampliar a presença da empresa nesses países”, explica André Martins, gerente geral da Koppert Andina.
Com a integração dos bioinsumos produzidos no Brasil ao portfólio comercializado na América do Sul, a Koppert espera alcançar um aumento de 10% em seu faturamento local. Atualmente, a equipe que atua nos países andinos é composta por cerca de 30 colaboradores, mas espera-se que esse número aumente significativamente a partir de 2026.
O mercado agrícola dos países andinos tem suas peculiaridades, com foco na produção de frutas, plantas ornamentais, hortaliças em cultivo protegido, café e cana-de-açúcar. Mesmo assim, a Koppert continuará oferecendo uma ampla gama de produtos, incluindo cerca de
30 bioinsumos importados da Holanda. Além disso, três produtos biológicos brasileiros - Trichodermil (Trichoderma harzianum 1306), Boveril Evo (Beauveria bassiana) e Octane (Isaria fumosorosea 1296) - serão introduzidos no mercado andino, demonstrando o compromisso da empresa em fornecer soluções inovadoras e sustentáveis para os agricultores da região

Esta expansão de negócios marca um novo capítulo na história da Koppert, consolidando sua posição como líder em soluções de controle biológico na região.
6
Danilo Pedrazolli, Diretor Industrial, ao lado de Gustavo Herrmann, Diretor Comercial da Koppert Brasil

7 BioJournal | Ano 11 | Edição 01 | TRIMESTRAL 2024
INVESTIMENTO
Koppert recebe investimento estratégico da HAL Investments para expandir sua atuação global
A Koppert, empresa importante no fornecimento de soluções sustentáveis para horticultura e agricultura, anunciou recentemente um investimento estratégico da HAL Investments, no valor de 140 milhões de euros em capital social preferencial. Esta injeção de capital visa impulsionar o crescimento da empresa e fortalecer sua posição como líder no setor de soluções biológicas agrícolas.
Com uma rede internacional de subsidiárias e diversas instalações de produção em todo o mundo, a Koppert tem como objetivo promover práticas agrícolas mais saudáveis, seguras e produtivas. Por meio de um sistema integrado de conhecimento especializado e soluções naturais, a empresa busca melhorar a saúde e a produção das culturas.
O investimento da HAL Investments será direcionado principalmente para a expansão das instalações de produção e capital de giro da Koppert, visando

apoiar o crescimento global da empresa. Além disso, essa parceria estratégica abre portas para investimentos futuros e fortalece a posição da Koppert no mercado de licenciamento e fusões e aquisições.
René Koppert, CEO da Koppert, expressou sua satisfação com a parceria: “Temos o prazer de receber a HAL Investments como parceiro estratégico e investidor de longo prazo. Juntos, Koppert e HAL compartilham a visão de promover mudanças positivas. Esta colaboração irá acelerar as nossas iniciativas de pesquisa e desenvolvimento, impulsionando a criação de soluções de ponta para a agricultura biológica e sustentável.”
Com o apoio da HAL Investments, a Koppert espera acelerar seu crescimento e causar um impacto ainda mais significativo na agricultura global, fornecendo soluções inovadoras e sustentáveis para os desafios do setor.
Esta colaboração irá acelerar as nossas iniciativas de pesquisa e desenvolvimento, impulsionando a criação de soluções de ponta para a agricultura biológica e sustentável.

René
Koppert CEO da Koppert
8
Matriz da Koppert na Holanda
RECONHECIMENTO
Prêmio de Inovação
Tecnológica: Koppert é Reconhecida na Fruit Logistica
A Koppert recebeu reconhecimento internacional por sua excelência em inovação durante a Fruit Logistica, o evento global mais significativo para a indústria de produtos frescos e frutas. A empresa foi agraciada com o Prêmio de Inovação Tecnológica por seu avançado sistema de liberação do produto Mirical (Macrolophus pygmaeus), desenvolvido pela Koppert holandesa.
O novo sistema não apenas aprimora a precisão da aplicação do inseto predador, mas também demonstra um compromisso firme com a sustentabilidade, reduzindo o uso
de plástico em 99%. Essa conquista representa um marco significativo no setor agrícola, destacando a liderança da Koppert em tecnologia e inovação.
Desde sua fundação em 1967, a Koppert tem sido pioneira em Pesquisa & Desenvolvimento, dedicandose incansavelmente à criação de soluções que tornam a agricultura mais sustentável, rentável e produtiva. O reconhecimento deste prêmio reforça o compromisso contínuo da empresa em promover práticas agrícolas ambientalmente responsáveis e eficientes.


A Koppert reitera seu lema: “Biológico é Koppert!” e continua a liderar o caminho para um futuro agrícola mais sustentável e próspero. Com um histórico comprovado de inovação e excelência, a empresa está comprometida em impulsionar a indústria agrícola rumo a novas fronteiras de sucesso e sustentabilidade.
Essa conquista representa um marco significativo no setor agrícola, destacando a liderança da Koppert em tecnologia e inovação.
9 BioJournal | Ano 11 | Edição 01 | TRIMESTRAL 2024
Representantes da Koppert recebem o prêmio “Inovação Tecnológica” durante o evento
Biológicos: A chave para o manejo eficaz da cigarrinhado-milho
A cigarrinha-do-milho é uma praga de grande desafio para os produtores, causando significativas perdas de produtividade e impactando diretamente o retorno econômico das lavouras. Espalhada desde o sul ao norte do país, essa praga é um problema crônico que afeta quase todas as regiões onde o cultivo de milho é presente, inclusive no Paraguai.
O controle da cigarrinha-do-milho requer estratégias eficientes e sustentáveis. É nesse contexto que um manejo integrado com produtos biológicos, como o fungo entomopatogênico Octane (Isaria fumosorosea 1296) da Koppert, desempenha um papel fundamental. Além de contribuir para um manejo mais equilibrado e sustentável, o Octane quebra a resistência da praga, ajudando a manter sua população sob controle. “Hoje a Koppert tem uma ferramenta que vem revolucionando muito bem

o mercado, para poder contribuir com o produtor para o manejo dessa praga”, diz Marcelino Brito, Gerente de Desenvolvimento de Mercado da Koppert Brasil, se referindo ao bioinseticida no combate à cigarrinha-domilho. Essa estratégia combinada com outras medidas, como um tratamento de semente adequado, a escolha de híbridos tolerantes e a programação da janela de plantio, contribui para minimizar os danos causados pela praga.
Vale ressaltar que a Isaria fumosorosea 1296, aplicada de acordo com a presença da praga, oferece uma solução eficaz não apenas para o controle da cigarrinha, mas também para outras pragas como tripes, ácaro-rajado, cochonilha-da-roseta, psilídeo-deconcha e psilídeo, sendo versátil em diversas culturas onde essas pragas são encontradas.

Cada saca de manejo investido resulta em um retorno econômico de 5 a 10 sacas de liquidez (...)

DESAFIO X SOLUÇÃO
Maurício Pasini Consultor e Pesquisador
10
O fungo entomopatogênico Octane (Isaria fumosorosea 1296) da Koppert


De acordo com Maurício Pasini, Consultor e Pesquisador, com a incorporação de um manejo integrado com o Octane, os produtores podem experimentar uma melhoria significativa na produtividade e na lucratividade de suas lavouras. “Cada saca de manejo investido resulta em um retorno econômico de 5 a 10 sacas de liquidez, e isso está relacionado, principalmente, à manutenção da população baixa da praga durante o desenvolvimento da cultura”, acrescenta Pasini.
Diante desse cenário, fica evidente que os biológicos são uma ferramenta essencial para o manejo integrado de pragas, oferecendo uma alternativa eficaz e sustentável para os desafios enfrentados pelos produtores no controle da cigarrinha-do-milho.

Acesse o canal da Koppert no YouTube e confira todas as soluções e conteúdos voltados ao manejo de milho e outras culturas!
11 BioJournal | Ano 11 | Edição 01 | TRIMESTRAL 2024
Imagens ilustrativas. Todos os direitos reservados.
Koppert Biotalks:
Recapitulando a primeira temporada e preparando-se para a próxima com Renata Maron

A apresentadora Renata Maron no cenário da 2ª temporada do Koppert Biotalks
A jornada do Koppert Biotalks tem sido uma viagem rica pelo mundo da agricultura sustentável, destacando práticas inovadoras, desafios e soluções para um futuro agrícola mais promissor. Contando com a presença de convidados diversificados e temas relevantes, a primeira temporada trouxe insights valiosos e perspectivas inspiradoras para os produtores e entusiastas do setor. Que tal fazermos uma rápida retrospectiva?
O episódio inaugural da primeira temporada do Koppert Biotalks, lançado em 5 de janeiro, contou com a presença de Eduardo Leão de Sousa, CEO da CropLife Brasil. Práticas agrícolas sustentáveis e o impacto das biotecnologias na agricultura foram discutidos. Em 10 de janeiro, Marcelino Borges de Brito e Glauber Renato Stürmer trouxeram insights
sobre os desafios e oportunidades do controle biológico na agricultura brasileira. O terceiro episódio contou com a presença de Renata Potenza, do Imaflora, que compartilhou reflexões sobre o desenvolvimento de sistemas produtivos sustentáveis e a redução das emissões de carbono. Rodrigo Lima, da Agroicone, participou do Biotalks no dia 17 de janeiro e destacou a visão de futuro da agricultura brasileira e a implementação de ações sustentáveis. Já Marcelino Borges de Brito e Mariana Ferreira Rabelo Fernandes, no dia 29 de janeiro, exploraram os benefícios do bioativador para a sustentabilidade da lavoura. Encerrando a primeira temporada com chave de ouro em 21 de fevereiro, o convidado foi o Dr. José Roberto Postali Parra, do Sparcbio, que abordou o papel da pesquisa na ampliação do acesso ao controle biológico.
Agora, convidamos você para acompanhar a próxima temporada do Koppert Biotalks que se iniciou! Os primeiros episódios já estão disponíveis: novos convidados, temas relevantes e discussões estimulantes aguardam por você.
Junte-se a nós enquanto continuamos nossa busca por um futuro agrícola mais sustentável e próspero.
Escaneie o QRCode e assista a nova temporada do Koppert BioTalks.

NOVA TEMPORADA
12
HOMENAGEM
Dia Internacional das Mulheres: Reconhecendo o Papel Fundamental das Mulheres no Agronegócio
No Dia Internacional das Mulheres, a Koppert promoveu uma série de ações para homenagear e reconhecer a importância das mulheres no setor agrícola. Em uma iniciativa especial, algumas mulheres das unidades da Koppert América do Sul foram selecionadas para representar toda essa classe de profissionais do agro.
Através do olhar dessas mulheres e de tantas outras que contribuem diariamente para tornar a agricultura mais sustentável, a Koppert celebra o talento, dedicação e trabalho dessas profissionais. O Dia Internacional das Mulheres é uma oportunidade não apenas de reconhecer as conquistas das mulheres, mas também de refletir sobre os desafios que ainda enfrentam no campo.
Neste contexto, é importante destacar a força da mulher que nutre a agricultura. Com sua presença marcante e sua

Agro Rosário e no Koppert Experience, como um gesto simbólico de apreço e reconhecimento pela contribuição das mulheres para o desenvolvimento do agronegócio. Essa ação não apenas celebrou o Dia Internacional das Mulheres, mas também destacou a importância de promover um ambiente de trabalho inclusivo e diversificado.
A Koppert reafirma seu compromisso em continuar apoiando e valorizando as mulheres em todas as esferas do agronegócio, reconhecendo sua inestimável contribuição para a agricultura sustentável e produtiva.

13 BioJournal | Ano 11 | Edição 01 | TRIMESTRAL 2024
DESAFIO X SOLUÇÃO
Metarril
(Metarhizium anisopliae E9): Controle eficiente da cigarrinha-da-raiz
O Metarril (Metarhizium anisopliae E9) tem se destacado como um bioinseticida microbiológico altamente eficaz no controle da cigarrinha-da-raiz (Mahanarva fimbriolata), uma praga que afeta diversas culturas. Com uma formulação inovadora e eficiente, o Metarril oferece uma dose certa para o combate a essa praga, proporcionando uma solução segura e sustentável para os agricultores.
Este bioinseticida atua em diferentes estágios do ciclo de vida da cigarrinhada-raiz, garantindo uma proteção abrangente e duradoura das plantações. Além disso, o Metarril pode ser utilizado em qualquer cultura onde a cigarrinhada-raiz esteja presente, oferecendo uma solução versátil e adaptável às necessidades dos produtores.

Entre os principais benefícios do produto, destacam-se:
1) Ideal para Manejo Integrado de Pragas (MIP)
O Metarril é uma ferramenta fundamental para o Manejo Integrado de Pragas, permitindo o controle eficaz da cigarrinha-da-raiz enquanto preserva o equilíbrio do ecossistema agrícola.

2) Indicado para Manejo de Resistência de Insetos-Praga a Inseticidas Químicos
O uso contínuo de inseticidas químicos pode levar ao desenvolvimento de resistência por parte das pragas. O Metarril oferece uma alternativa eficaz para o manejo dessa resistência, ajudando os agricultores a diversificar suas estratégias de controle de pragas.
3) Preserva os Inimigos Naturais das Pragas
Ao contrário dos inseticidas químicos, que muitas vezes têm efeitos colaterais prejudiciais aos inimigos naturais das pragas, o Metarril preserva a biodiversidade do ambiente agrícola, contribuindo para um ecossistema mais equilibrado e saudável.
14


Com o Metarril, os agricultores podem contar com uma solução eficiente e sustentável para o controle da cigarrinha-daraiz, garantindo assim a saúde e a produtividade de suas plantações.
Praga (Mahanarva fimbriolata) colonizada pelo Metarril®, na cultura da cana-de-açúcar no interior de São Paulo. Foto: acervo Koppert Brasil.
Imagens ilustrativas. Todos os direitos reservados.
15 BioJournal | Ano 11 | Edição 01 | TRIMESTRAL 2024
SUSTENTABILIDADE
Parceria estratégica para uma agricultura sustentável firmada entre Koppert e IBRAHORT
A Koppert e o Instituto Brasileiro de Horticultura (IBRAHORT) anunciaram uma parceria estratégica com o objetivo de promover práticas sustentáveis na agricultura. Essa união visa aprofundar o entendimento sobre o setor de horticultura e alinhar estratégias para contribuir de forma mais efetiva com os agricultores, especialmente no uso consciente de bioinsumos.
De acordo com Fernando Gilioli, Gerente de Marketing Regional da Koppert, “através dessa iniciativa com o IBRAHORT, estamos colocando a Koppert na vanguarda com os grandes produtores da cadeia de horticultura no Brasil”. Gilioli destaca ainda que essa parceria proporcionará à Koppert acesso direto à cadeia da horticultura, enquanto ajuda o setor a compreender e utilizar melhor os biológicos, atendendo às crescentes demandas dos consumidores por práticas mais sustentáveis.


A primeira ação conjunta aconteceu no dia 19 de abril, durante o 2º Encontro Nacional IBRAHORT, em Holambra (SP). Na ocasião, a Koppert apresentou a palestra “Bioinsumos, movimento inovador na proteção de plantas”, abordando a importância e os benefícios dos bioinsumos na horticultura.
Para formalizar a parceria, Manoel Oliveira, Diretor da IBRAHORT, visitou a sede da Koppert em Piracicaba (SP), onde foram discutidos os compromissos mútuos e planejadas as ações conjuntas para o ano.
Essa parceria reforça o compromisso da Koppert e do IBRAHORT com uma agricultura mais sustentável, eficiente e produtiva, proporcionando benefícios tanto para os produtores quanto para o meio ambiente.
16
Felipe Itihara, Gerente de Inovações, Alexandre Mistrelo, Coordenador de Inteligência de Mercado e Fernando Gilioli, Gerente de Marketing Regional receberam Manoel Oliveira, Diretor do IBRAHORT
Confira as visitas que recebemos no último trimestre RECEPTIVO KOPPERT

Nosso receptivo recebeu parceiros, clientes e especialistas, que visitaram as unidades de produção da Koppert em Piracicaba (SP) e Charqueada (SP). O projeto visa apresentar a estrutura e qualidade Koppert aos visitantes, que têm a oportunidade de conhecer os laboratórios de Pesquisa & Desenvolvimento e as fábricas de micro, macrobiológicos e de formulações.
Agradecemos a presença dos representantes da Coplacana e Usina da Pedra (30/01), Suprema Agro, Soma Agropecuária (21/02), Governo do Québec, Agroazul (21/02), Grupo Viterra (29/02), Valor Agrícola, Fazendas HP, FC Consultoria, Apoio Agrícola e Fazenda Invernadinha (05/03).




30/Jan 29/Fev 05/Mar 21/Fev 21/Fev 17 BioJournal | Ano 11 | Edição 01 | TRIMESTRAL 2024
FEIRAS E EVENTOS
A presença da Koppert se destaca nos eventos das principais regiões produtoras do Brasil
10 a 12 de janeiro
Dinetec (Canarana/MT)
Koppert marca presença nos maiores eventos, feiras e congressos do agronegócio brasileiro. Ao lado de parceiros, consultores e pesquisadores, leva as vantagens do controle biológico para todas as regiões do Brasil. Confira abaixo:


11 e 12 de janeiro
Open Sky Soja (Sorriso/MT)

18
17 e 18 de janeiro
Safratec (Londrina/PR)

23 a 25 de janeiro
Dia de Campo Lar (Medianera/PR)


31 de janeiro a 02 de fevereiro
Agrotec Integrada (Assaí/PR)

19 BioJournal | Ano 11 | Edição 01 | TRIMESTRAL 2024
FEIRAS E EVENTOS

30 de janeiro a 02 de fevereiro
Belasafra (Cambé/PR)

17 de fevereiro
Dia de Campo PA Consultoria (Tangará da Serra/MT)


19 a 23 de fevereiro
Congresso Brasileiro de Micologia (Belo Horizonte/MG)
20
21 e 22 de fevereiro
Show Tecnológico de Verão
(Ponta Grossa/PR)

27 a 29 de fevereiro
Show Tecnológico
Copercampos (Campos Novos/SC)


06 e 07 de março
Datagro - abertura de safra
(Ribeirão Preto/SP)
26 de fevereiro a 01 de março
Coplacampo
(Piracicaba/SP)

21 BioJournal | Ano 11 | Edição 01 | TRIMESTRAL 2024
FEIRAS E EVENTOS
07 a 09 de março
Koppert Experience
(Rio Quente/GO)





22
07 a 09 de março
AgroRosário
(Correntina/BA)

18 a 22 de março
Showsafra
(Lucas do Rio Verde/MT)



12 a 15 de março
FarmShow
(Primavera do Leste/MT)
14 e 15 de março
RAV Adubos Real
(Itapeva/MG)

23 BioJournal | Ano 11 | Edição 01 | TRIMESTRAL 2024
PARAGUAI
Koppert lança
Trichodermil
1306 (Trichoderma harzianum) com nova formulação FS para Tratamento de Sementes no Paraguai

Líder global em soluções biológicas para agricultura, a Koppert participou do evento Noite de Campo da Somax Agro, realizado em 13 de março em San Alberto, Paraguai. O evento reuniu renomados palestrantes e entusiastas do setor agrícola para um dia de inovações no campo, proporcionando uma excelente oportunidade para destacar os benefícios dos bioinsumos.
Durante o evento, a multinacional holandesa revelou ao público e parceiros o lançamento do Trichodermil 1306 (Trichoderma harzianum), com a inovadora formulação Suspensão Concentrada para Tratamento de Sementes. O produto está registrado no SENAVE sob número 7539.
Trichodermil 1306 já é uma marca reconhecida no Paraguai, porém, foi
aprimorado com uma nova versão especialmente desenvolvida para Tratamento de Sementes (TS) e Tratamento de Sementes Industrial (TSI), incorporando a tecnologia inovadora em sua formulação FS. Essa formulação proporciona dupla proteção às sementes contra fungos e nematoides fitopatogênicos do solo, com registro para: Fusarium solani, Rizoctonia solani e Pratyenchus zeae.
Entre os benefícios operacionais do Trichodermil 1306 estão sua formulação FS, que permite uma dose baixa e secagem rápida, além de ser altamente compatível com outros tratamentos e possibilitar o armazenamento das sementes tratadas por até 20 dias para Tratamento de Sementes e até 60 dias para Tratamento de Sementes Industrial antes da semeadura.
Para a lavoura, o Trichodermil 1306 com formulação FS oferece uma série de vantagens, incluindo maior proteção das raízes contra nematoides e fungos fitopatógenos, melhoria na saúde das culturas, aumento do desenvolvimento radicular, maior produtividade das plantas e, consequentemente, maior rentabilidade.
A Koppert reafirma seu compromisso com a agricultura sustentável e a saúde das plantas, proporcionando soluções inovadoras que contribuem para o sucesso e a rentabilidade dos agricultores no Paraguai e em todo o mundo.
24
ARGENTINA